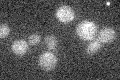

View description
Alpha 1,2-mannosyltransferase involved in glycosyl phosphatidyl inositol (GPI) biosynthesis; required for addition of the fourth, side branching mannose to the GPI core structure
Localization:
Intensity:
Fold change:
Significance:
-
C’ GFP library in SD

below threshold17.32 -
N' NOP1pr-GFP in SD

ER61.4114 -
N' TEF2pr-mCherry in SD

ER,punctate80.011 -
N' NATIVEpr-GFP in SD

below threshold14.957 -
N' TEF2pr-VC and Cyto-VN in SD

ER30.91 -
C’ GFP library in SD+DTT

cytosol17.020.98No -
C’ GFP library in SD+H2O2

cytosol14.620.84No -
C’ GFP library in Starvation Media
cytosol13.50.77No -
C’ GFP library on the background of Pup2-DaMP

below threshold -
C’ GFP library on the background of CCT mutant

below threshold18.51591.06869No
